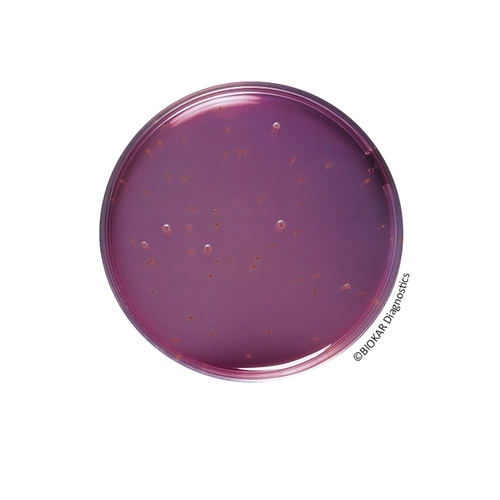
BCP Dextrose Agar

BCP Dextrose Agar
BCP Dextrose Tryptone Agar (also known as BCP Glucose agar) is used to enumerate mesophilic and thermophilic aerobic bacterial spores (especially Bacillus stearothermophilus, responsible for flat sour) in raw materials and in ingredients used in canning non-acid products (pH > 4,5). It is also used in surface samples and canning process water.
| Ürün Adı | BCP Dextrose Agar |
| Ürün Kodu | BM16808 |
| Miktar | 10 vials of 200 mL |